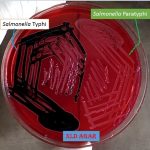
XLD agar with salmonella
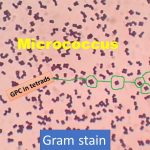
GPC in tetrads
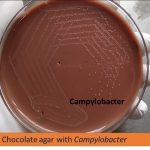
Chocolate agar

Collection Group: Clinical Bacteriology
XLD Agar: Introduction, Principle, Preparation, Test Procedure, Colony Characteristics and Limitations
Introduction of XLD Agar XLD agar is a selective, differential,...
Introduction of XLD Agar XLD agar is a selective, differential,...
Micrococcus Gram Stain: Introduction, Principle, Procedure and Result Interpretation
Introduction of Micrococcus Micrococcus in gram stain is showing -...
Introduction of Micrococcus Micrococcus in gram stain is showing -...
Chocolate agar with Campylobacter and its related informations
Campylobacter on chocolate agar (CHOC) Chocolate agar preparation and uses:...
Campylobacter on chocolate agar (CHOC) Chocolate agar preparation and uses:...
